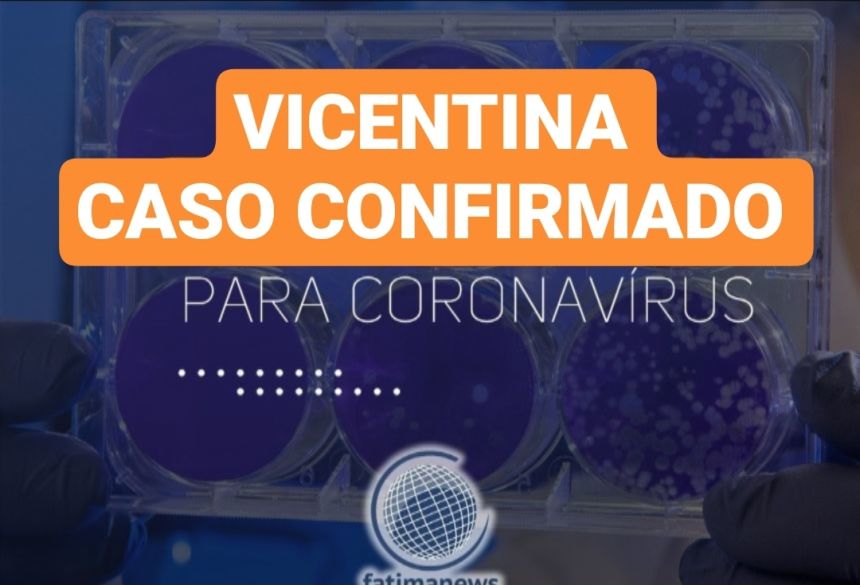

Regiaonline Há 6 anos
Regiaonline A Cura: Em Jateí, Paciente que superou Covid-19 fala, em Rede Social sobre Fé, Proteção Divina e Discriminação sofrida durante período de isolamento.
Regiaonline A Cura: Em Jateí, Paciente que superou Covid-19 fala, em Rede Social sobre Fé, Proteção Divina e Discriminação sofrida durante período de isolamento.